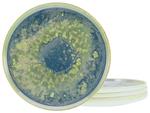
Набор обеденных тарелок yuki 4 предмета Creatable, мультиколор - фото

Бренд: Creatable
Цвет: мультиколор
Цвет: мультиколор
Показать еще
Наименование, описание и товарный знак приведены в информационных целях на основе данных официального зарубежного магазина.
Условия о вознаграждении Агента изложены в п. 2.3.4 Агентского договора.
При заказе в категориях одежды и обуви ориентируйтесь на «оригинальные» размеры производителей.
При заказе в категориях одежды и обуви ориентируйтесь на «оригинальные» размеры производителей.
Ваша цена
8 976₽
Пошлина ≈ оплачивается отдельно
из Германии
без переплат
Общая информация
- Диаметр: 28 см
- Форма: круглая
- Номер модели: 21508
- Название коллекции: YUKI
- Особенности: безопасен для пищевых продуктов
- Комплект состоит из: 4 шт.
- Высота ок.: 3 см
- Тип керамики: Керамика
- Материал: Керамика
- Диаметр 1: 28 см
- Инструкции по уходу: можно мыть в посудомоечной машине, можно использовать в микроволновой печи.
Владимир Л
У нас можно оплатить заказ банковской картой.
Мы принимаем:
Доставка товаров осуществляется курьером или на пункт выдачи заказов.
Удобный способ доставки можно выбрать при оформлении заказа.
Срок доставки может увеличиваться в зависимости от особенностей международных перевозок и региона доставки.
Условия об ориентировочных сроках доставки указаны в правилах пользования и условиях агентского договора.

Набор обеденных тарелок yuki 4 предмета Creatable, мультиколор
8 976₽